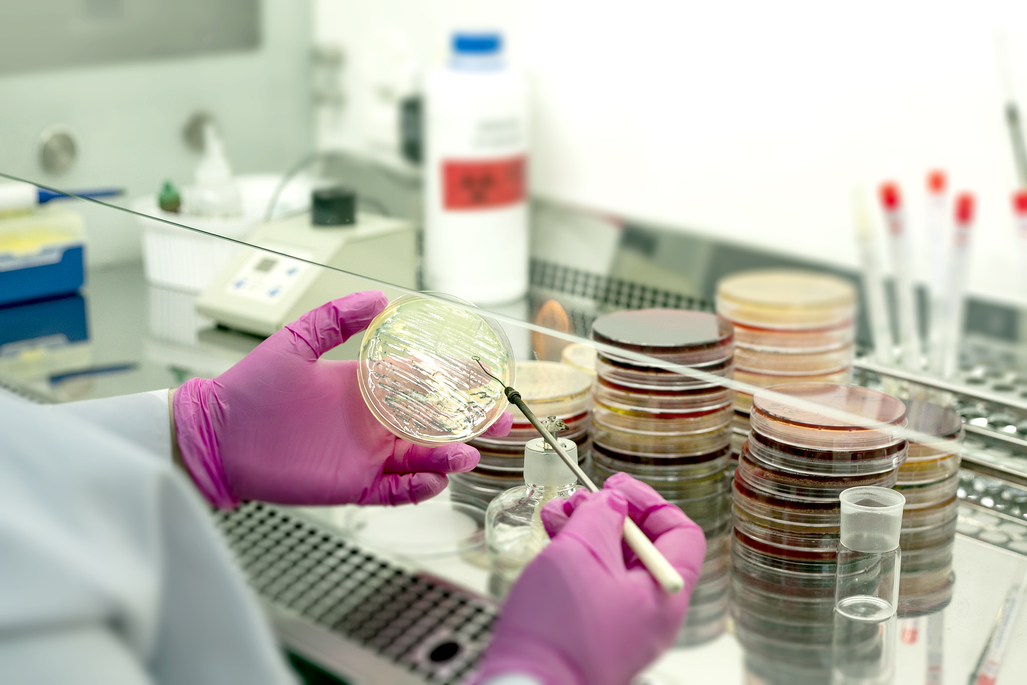

БЕЗБОЛЕЗНЕННОЕ И БЕЗОПАСНОЕ ВЗЯТИЕ КРОВИ
Для безболезненного и безопасного забора крови из труднодоступных и тонких вен мы используем специальные иглы-бабочки класса премиум австрийской компании Greiner, что позволяет обеспечить полный комфорт пациента и получить максимально точные результаты исследований.